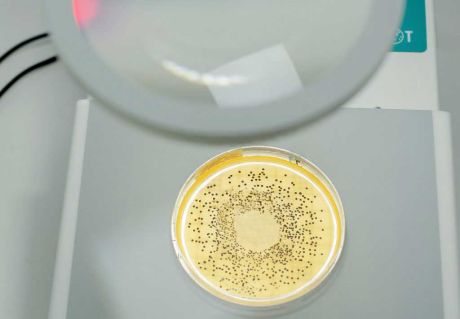
IUL COLONY COUNTER manual colony counter

-
Instruments, devices
-
Stirrers, shakers, centrifuges
Magnetic stirrers Overhead stirrers Stirrers, shakers Centrifuges FlocculatorsHeating and thermostatic devices
Heating plates Block heaters, digestion units Heating mantles Circulating thermostats Drying ovens, hot air sterilizers Incubators Vacuum drying ovens Climate and test chambers FurnacesRefrigerators and freezers
Refrigerators, freezers ULT freezers Portable coolers Ice makers Recirculation coolersEvaporating and water distilling devices
Water baths Rotary vacuum evaporators Water distillers Kjeldahl Distillations Water purifiersAnalyzers
Mercury determining device Protein determining device Fat determining device Fiber analyzers Chromatographs Element analyzers Thermogravimetry TGA
-
-
Glassware
-
Plasticware
-
-
Metalware
-
Safety, hygiene
-
Filtration
-
Liquid dispensers
-
Sample preparation
- Microwave
-
Microbiology
-
Standards
-
Instruments, devices
-
Stirrers, shakers, centrifuges
Magnetic stirrers Overhead stirrers Stirrers, shakers Centrifuges FlocculatorsHeating and thermostatic devices
Heating plates Block heaters, digestion units Heating mantles Circulating thermostats Drying ovens, hot air sterilizers Incubators Vacuum drying ovens Climate and test chambers FurnacesRefrigerators and freezers
Refrigerators, freezers ULT freezers Portable coolers Ice makers Recirculation coolersEvaporating and water distilling devices
Water baths Rotary vacuum evaporators Water distillers Kjeldahl Distillations Water purifiersAnalyzers
Mercury determining device Protein determining device Fat determining device Fiber analyzers Chromatographs Element analyzers Thermogravimetry TGA
-
-
Glassware
-
Plasticware
-
-
Metalware
-
Safety, hygiene
-
Filtration
-
Liquid dispensers
-
Sample preparation
- Microwave
-
Microbiology
-
Standards
IUL COLONY COUNTER, manual colony counter
IUL
Request a price
A petri dish with an outer diameter of 60, 80, 90, 100, or 120 mm can be placed on the colony counting device - with a suitable adapter - which is illuminated from above (if a dark background is required) or from below (if colonies on a transparent culture medium are to be counted).
Colonies are counted with a felt-tip pen, which marks the counted colonies on the petri dish. The unit number can also be read on the device's digital display. Before starting to count new (other) colonies, the counter of the colony counting device can be reset by pressing a button. In addition to the marking felt, the device with two inputs also has a marker with a metal tip.
Accessories: 90 mm petri dish adapter, evaluation grid set (foil)
| Specifications: | COLONY |
|---|---|
| Colony count: | 0 – 9999 pc |
| Magnifying glasses | Ø100 or Ø120 mm, biconvex, 4 diopter, DINx2 |
| Dimensions: | 200 x 400 x 300 mm |
| Weight: | 3 kg |
related products
SphereFlash automatic colony counter with patented illumination
More informationsWLD-TEC's GASPROFI 1 MICRO SCS type safety gas burner is the smallest device available for this purpose
More informations